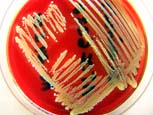
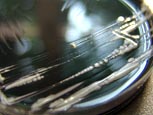

Regie: Dominique Hennequin
2010; GEO-Reportage, 52 Min.
Produktion: Medienkontor/Arte

| Michelle Barbin - FilmSchnitt | ||||||
Tel.: +49 +30 60 50 68 58 mobil: +49 +172 42 42 902 eMail: mail[at]michelebarbin.de |
||||||
| Home | Dokumentarfilm | Spielfilm + TV | Serie | Werbung | ||
 |
CHAMPAGNER FÜR ALLE Regie: Dominique Hennequin 2010; GEO-Reportage, 52 Min. Produktion: Medienkontor/Arte |
 |
 |
SCHMUCK DER STRASSE Regie: Rosa Baches 2010; Doku; 75 Min. Produktion: dirkmanthey film / Chroma Vision / Nächster Halt Filmproduktion |
 |
 |
ST. PIERRE ET MIQUELON, DIE VERLORENE INSEL Regie: Laurent Cistac 2009; GEO-Reportage; 52 Min. Produktion: Medienkontor/Arte |
 |
|
| © Laurent Cistac | © Laurent Cistac |
|
MRSA, DIE VERSCHWIEGENE SEUCHE Regie: Monika Hielscher & Matthias Heeder 2009; Doku, Themenabend Arte; 58 Min. Produktion: Medienkontor/Arte |
|